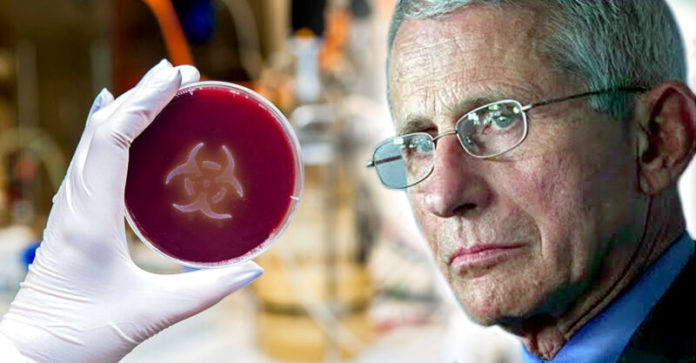

Robert F. Kennedy otkriva kako je Fauci, glavni američki ” stožeraš” iz lažne pandemije covida eksperimentirao, mučio i ubijao nevinu siročad koja nisu imala roditelje ili skrbnike da ih zaštite. Dao je njihova tijela pokopati u masovnu neobilježenu grobnicu kako nitko ne bi saznao.
“Tony Fauci se pobrinuo da nitko od te djece nema staratelje što je protuzakonito, a onda je sakrio što radi u eksperimentima. Uzeo je udomitelje u 6 država i predao se farmaceutskoj industriji.”
“Pobrinuo se da ljudi koji su vodili te udomiteljske domove nemaju čak ni medicinsko obrazovanje. Većina njih su bili imigranti koji su došli iz Dominikanske Republike. Nisu znali ništa o medicini ili odgovornostima, a bili su bolesni.”
“I kad su polako shvatili u što su uključeni da rade toj djeci, da su tu djecu mučili. I, znate, tu su video snimke te djece, stari BBC-jev dokumentarac koji će vas rasplakati.”
“Obećavam vam, ne možete ovo gledati bez plača. Znate, jedan od ove djece, 12-godišnjak, koji pokušava zaštititi 8-godišnjaka, i ima cijev u želucu. I on im govori, znaš, pokušao sam se boriti protiv njih, i to je ono što oni rade.”
“Ako se borite protiv njih, ne možete se boriti protiv njih. Trebate samo uzeti lijekove, a djeca ih nisu htjela uzimati jer su ih lijekovi činili užasno bolesnima. A Celia Farber bila je nevjerojatna istraživačica koja je radila na ovome poglavlje za mene i napravio sam puno izvornog istraživanja o njemu.”
“Zapravo je otišla u Hawthorne, New York na groblje Gates of Heaven. Pronašla je groblje gdje je Fauci odlagao leševe te djece koja su umrla u njegovim ilegalnim eksperimentima.”
“Pronašla je otvorenu jamu. Bila je zapravo prekrivena, astroturf tepihom. Otvorila je astroturf tepih i vidjela je stotine i stotine sićušnih malih lijesova nasumično naslaganih jedan na drugi jer su to djeca koja nemaju roditelje i nikoga bio tu da ih zaštiti.”
“A Tony Fauci ih je tretirao kao kolateralnu štetu, i, znate, njegov cilj je bio povećati tržišta za ove farmaceutske tvrtke s kojima je bio partner dopuštajući da se HIV, ti se toksični lijekovi za kemoterapiju daju djeci.”
“I zatim sljedeći eksperimenti, koji su u sljedećem poglavlju, koji su jednako užasni, njegovi su eksperimenti u Africi.”
HOP
HOP -portal na Telegramu